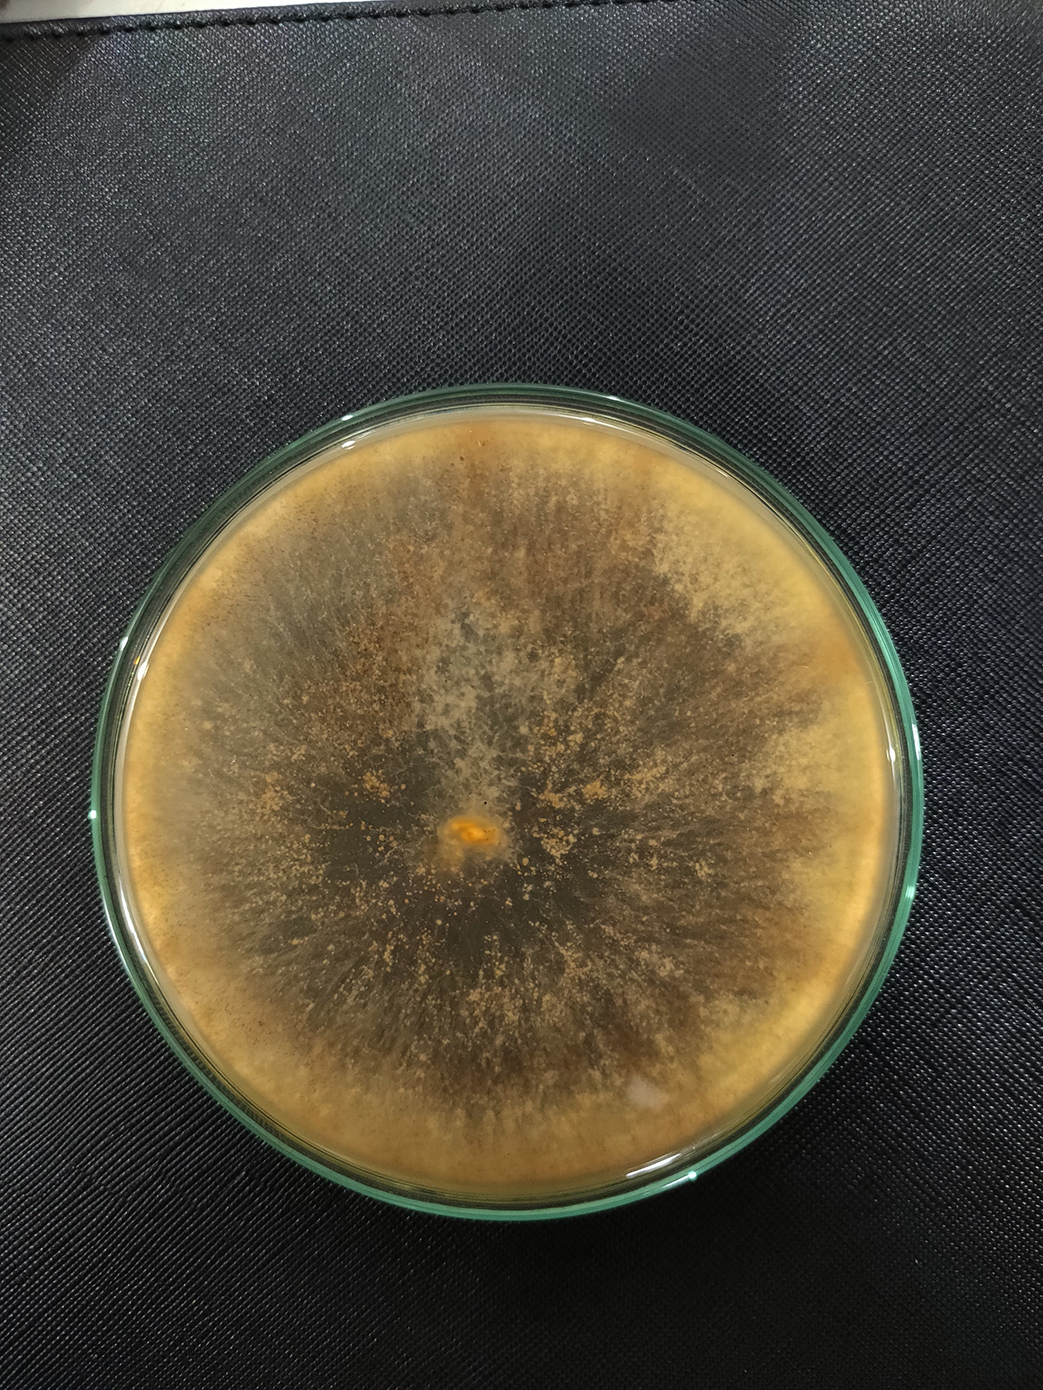

Ένας επιστήμονας υπόσχεται ότι βρίσκεται ένα βήμα πριν τελειοποιήσει το τρόφιμο του μέλλοντος, αποτελούμενο από τον μύκητα Neurospora, που εντοπίζεται σε πολλά φαγητά.
Ο Vayu Hill-Maini, πρώην σεφ, εγκατέλειψε τις κουζίνες για να γίνει χημικός, ώστε να ανακαλύψει έναν τρόπο να αντιμετωπιστεί η επισιτιστική κρίση. Σε συνεργασία με διάσημους σεφ εξερεύνησαν τις δυνατότητες μυκήτων όπως ο Neurospora intermedia, επεξεργαζόμενοι απόβλητα τροφίμων.
Για αυτό τον λόγο μελέτησαν την ασιατική κουζίνα, καθώς στα πιάτα της εντοπίζονται αρκετοί μύκητες που μπορούν να αξιοποιηθούν. Έτσι, κατέληξαν στον παραπάνω μύκητα που χρησιμοποιείται εδώ και αιώνες στην Ινδονησία για την παραγωγή του oncom, ενός ζυμωμένου τροφίμου που παρασκευάζεται από πολτό σόγιας.
«Το oncom κυκλοφορεί σε δύο ποικιλίες, μία κόκκινη και μία μαύρη. Το κόκκινο παράγεται από τη ζύμωση του πολτού σόγιας που έχει απομείνει από την παραγωγή τόφου, ενώ το μαύρο παράγεται από πρέσες φυστικέλαιου», έγραψε δημοσίευμα του Interesting Engineering.
Ο χημικός, λοιπόν, προχώρησε σε γενετικές μελέτες που αποκάλυψαν την παρουσία δύο νέων μορφών Neurospora. Η πρώτη μορφή ήταν άγρια στελέχη και η δεύτερη, στελέχη τα οποία προσαρμόστηκαν να επιβιώνουν σε γεωργικά απόβλητα. Χάρη στην ικανότητα των δεύτερων στελεχών να διασπούν την κυτταρίνη, μπορούν να μετατρέψουν τα απόβλητα σόγιας και φιστικιών σε ένα γευστικό τρόφιμο.
Με βάση τον Vayu Hill-Maini, ο μύκητας Neurospora intermedia είναι η ιδανική επιλογή για την παραγωγή τροφής μέσω αποβλήτων τροφίμων, γιατί μπορεί να αναπτυχθεί σε 30 διαφορετικούς τύπους γεωργικών αποβλήτων χωρίς να παράγει τοξίνες. Αυτά τα απόβλητα περιλαμβάνουν μπαγάς (ίνα που μένει μετά την έκθλιψη χυμού) από ζαχαροκάλαμο, πυρήνες ντομάτας, φλούδες αμυγδάλου και φλούδες μπανάνας.
Το πείραμα που δημιουργεί ελπίδες
Ο Vayu Hill-Maini, προκειμένου να αποδείξει ότι το πιάτο που έφτιαξε, μπορεί να καταναλωθεί από το ευρύ κοινό, συνεργάστηκε με τον σεφ Rasmus Munk για τη διεξαγωγή ενός πειράματος.
Συγκεκριμένα, κάλεσαν σε δείπνο 60 άτομα, χωρίς να τους πουν τι φαγητό θα έτρωγαν, αλλά ούτε και από ποια υλικά θα αποτελούνταν. Στους συμμετέχοντες δόθηκε ένα κόκκινο oncom και η γεύση του περιγράφηκε θετικά ως «γήινη, ξηρή και μανιταρένια».
Προκειμένου να υπάρξει αυτό το αποτέλεσμα, ο Rasmus Munk συνδίασε το Neurospora με ξηρούς καρπούς και κουκουνάρια, ώστε να αποκτήσει γεύση. Επιπλέον, ετοίμασε ως επιδόρπιο ένα καναπεδάκι από ζελεδάτο κρασί δαμάσκηνου που καλύφθηκε με κρέμα ρυζιού χωρίς ζάχαρη, η οποία είχε εμβολιαστεί με Neurospora, ζυμωθεί για 60 ώρες και στη συνέχεια σερβιρίστηκε κρύο με ένα σιρόπι λάιμ από καβουρδισμένη φλούδα λάιμ.

«Αντιληφθήκαμε ότι η διαδικασία άλλαξε τα αρώματα και τις γεύσεις με αρκετά δραματικό τρόπο, προσθέτοντας γλυκά, φρουτώδη αρώματα. Το βρήκα εκπληκτικό να ανακαλύπτω ξαφνικά γεύσεις όπως μπανάνα και φρούτα τουρσί χωρίς να προσθέσω τίποτα άλλο εκτός από τους ίδιους τους μύκητες», είπε ο σεφ.
Πλέον, ο Vayu Hill-Maini εξετάζει τους τρόπους παραγωγής του συγκεκριμένου φαγητού και το συνολικό κόστος, ευελπιστώντας σε λίγα χρόνια να έχει έτοιμο το φαγητό του μέλλοντος, που θα βάλει τέλος στην επισιτιστική κρίση.